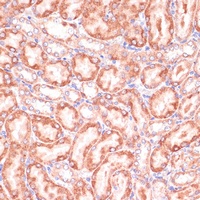
PGD Rabbit Polyclonal Antibody

You have no items in your shopping cart.
Human PGD Protein
SKU: orb753051
Description
Images & Validation
−
| Application Notes |
|---|
Key Properties
−| Source | Escherichia Coli |
|---|---|
| Biological Activity | Specific activity is > 10unit/mg. One unit will oxidize 1.0 umole of 6-phospho-D-gluconate to D-ribulose 5- phosphate per minute at pH 8.0 at 25˚C, in the presence of beta-NADP. |
| Protein Sequence | MGSSHHHHHH SSGLVPRGSH MAQADIALIG LAVMGQNLIL NMNDHGFVVC AFNRTVSKVD DFLANEAKGT KVVGAQSLKE MVSKLKKPRR IILLVKAGQA VDDFIEKLVP LLDTGDIIID GGNSEYRDTT RRCRDLKAKG ILFVGSGVSG GEEGARYGPS LMPGGNKEAW PHIKTIFQGI AAKVGTGEPC CDWVGDEGAG HFVKMVHNGI EYGDMQLICE AYHLMKDVLG MAQDEMAQAF EDWNKTELDS FLIEITANIL KFQDTDGKHL LPKIRDSAGQ KGTGKWTAIS ALEYGVPVTL IGEAVFARCL SSLKDERIQA SKKLKGPQKF QFDGDKKSFL EDIRKALYAS KIISYAQGFM LLRQAATEFG WTLNYGGIAL MWRGGCIIRS VFLGKIKDAF DRNPELQNLL LDDFFKSAVE NCQDSWRRAV STGVQAGIPM PCFTTALSFY DGYRHEMLPA SLIQAQRDYF GAHTYELLAK PGQFIHTNWT GHGGTVSSSS YNA |
| Purity | Greater than 90.0% as determined by SDS-PAGE. |
Storage & Handling
−| Storage | Stability: Store at 4°C if entire vial will be used within 2-4 weeks. Store, frozen at -20°C for longer periods of time. For long term storage it is recommended to add a carrier protein (0.1% HSA or BSA).Avoid multiple freeze-thaw cycles |
|---|---|
| Form/Appearance | Sterile Filtered colorless solution. |
| Buffer/Preservatives | The PGD solution (1mg/ml) contains 10% Glycerol, 1mM DTT, 0.1M NaCl, and 20mM Tris-HCl buffer (pH 8.0). |
| Expiration Date | 6 months from date of receipt. |
| Disclaimer | For research use only |
Alternative Names
−EC 1.1.1.44, 6PGD, PGDH, 6-phosphogluconate dehydrogenase decarboxylating, PGD.
Similar Products
−Human Phosphoglycerate Dehydrogenase (PHGDH) ELISA Kit [orb1736510]
Human
0.32-20 ng/mL
0.14 ng/mL
96 T, 48 THuman Prostaglandin D2 Synthase (PGDS2) ELISA Kit [orb1947367]
Human
62.5-4000pg/mL
37.5 pg/mL
48 T, 96 TPGD Rabbit Polyclonal Antibody [orb381952]
IHC, WB
Human, Mouse, Rat
Rabbit
Polyclonal
Unconjugated
50 μl, 100 μl, 200 μl, 30 μl

Quality Guarantee
Explore bioreagents carefree to elevate your research. All our products are rigorously tested for performance. If a product does not perform as described on its datasheet, our scientific support team will provide expert troubleshooting, a prompt replacement, or a refund. For full details, please see our Terms & Conditions and Buying Guide. Contact us at support@biorbyt.com.
Documents Download
Datasheet
Product Information
Request a Document
Protocol Information
Human PGD Protein (orb753051)
Based on 0 reviews
Participating in our Biorbyt product reviews program enables you to support fellow scientists by sharing your firsthand experience with our products.
Login to Submit a Review